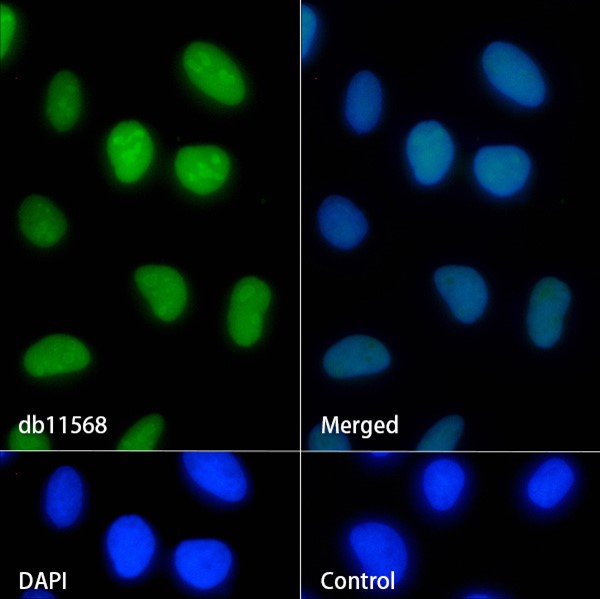

您当前的位置:
HMGB1 (DGR12117) Rabbit mAb (PBS Only)
db11568-PBS
Datasheet
Conjugation/Formulation:PBS Only
- Background This gene encodes a protein that belongs to the High Mobility Group-box superfamily. The encoded non-histone, nuclear DNA-binding protein regulates transcription, and is involved in organization of DNA. This protein plays a role in several cellular processes, including inflammation, cell differentiation and tumor cell migration. Multiple pseudogenes of this gene have been identified. Alternative splicing results in multiple transcript variants that encode the same protein. [provided by RefSeq, Sep 2015]
- Immunogen A synthetic peptide of human HMGB1
-
Gene ID
3146
-
Swiss Prot
P09429
- Synonyms HMG1; HMG3; HMG-1; SBP-1
- Reactivity Human,Mouse,Rat
- Application WB, IHC-P, ICC/IF, FC
- Calculated MW 25 kDa
- Observed MW 25 kDa
- Host species Rabbit
- Clonality Monoclonal
- Clonality No. DGR12117
- Isotype IgG
- Purity Affinity Purification
- Conjugation Un-conjugated
- Concentration 1 mg/mL
- Formulation PBS Only
- Storage/Stability Store at -20°C. Recommended to aliquot into single-use vials. Supplied in 1X PBS (pH 7.4). BSA and Azide Free. Stable for 12 months from date of receipt.
-
 Western blot analysis of extracts from K562, C6, 3T3, HeLa cells and Rat brain tissue using db11568 at 1:1000.
Western blot analysis of extracts from K562, C6, 3T3, HeLa cells and Rat brain tissue using db11568 at 1:1000. -
 Western blot analysis of extracts from RAW264.7 cells and Rat spleen, Mouse kidney tissues using db11568 at 1:1000.
Western blot analysis of extracts from RAW264.7 cells and Rat spleen, Mouse kidney tissues using db11568 at 1:1000. -
 Immunohistochemical analysis of paraffin-embedded human tonsil using db11568 antibody.
Immunohistochemical analysis of paraffin-embedded human tonsil using db11568 antibody. -
Immunofluorescence analysis of HeLa cells labelling HMGB1 with db11568.
Immunofluorescence analysis of HeLa cells labelling HMGB1 with db11568.
The cells were fixed with 4% PFA (10min, RT) followed by treatment with 0.1% Triton X-100 (10min, RT), and blocked in 1% BSA/10% normal goat serum/0.3M glycine in 0.1% PBS-Tween 20 for 1h. The cells were then incubate with db11568 (1:100) at room temprature for 1h, followed by a further incubation at room temperature for 45min with Goat Anti Rabbit lgG (H+L)-AF488 db10005, shown in green). Nuclear DNA was labeled in blue with DAPI.
Control: Secondary antibody only.
订购信息
- Package Price (RMB)
- 10μg 2598
- 100μg 7858
- 货期:现货
相关产品
For research use only. Not intended for diagnostic.
